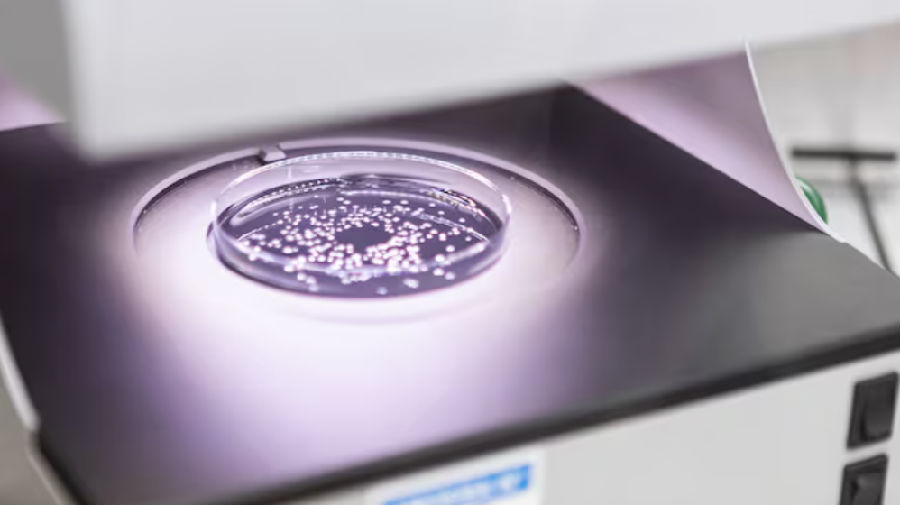
微信图片_2025-12-10_135945_645.png
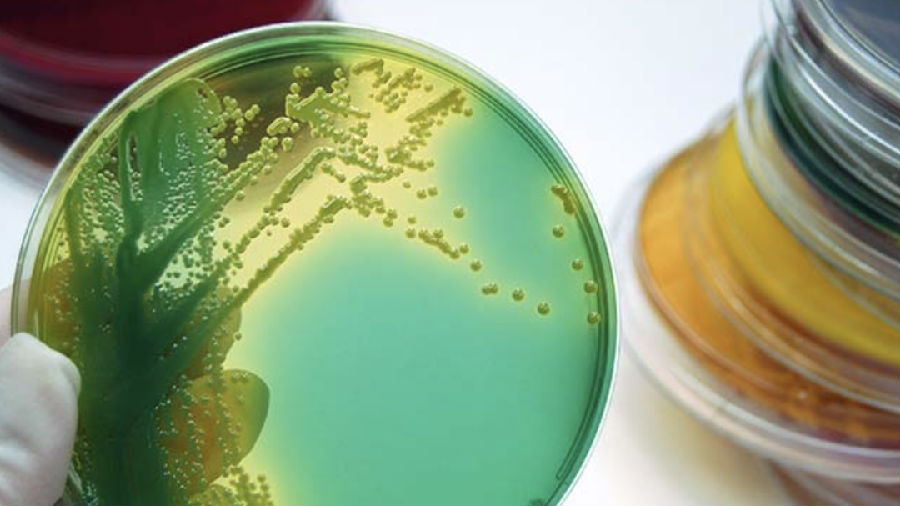
微信图片_2025-12-10_135952_359.png

一种单细胞生物,让先正达重新定义“农药”
致病真菌每年在欧洲高达1200万公顷的土地上肆虐,仅叶枯病一项就让德国农民损失15亿欧元。当传统化学农药因抗药性和监管压力节节败退之时,一个意想不到的“盟友”正从微观世界走来——变形虫。
先正达与法国生物技术公司Amoéba的联手,将这种单细胞生物的裂解物转化为新一代生物杀菌剂,不仅预示着作物保护策略的根本性转变,更揭示了农业生物技术领域正在发生的深刻变革。
01 技术突破与产业动向
这种基于Willaertia magna C2c Maky变形虫裂解物的生物杀菌剂,代表着农业生物技术的一个全新方向。与常规产品不同,它具备罕见的双重作用机制:既能直接抑制叶枯病、锈病和镰刀菌等病原菌的孢子萌发,展现直接的杀菌活性;又能激活植物的防御基因,诱导作物产生系统抗性。这种“主动防御+被动消杀”的组合拳,使其在预防病害发生的同时,还对已发生的感染具有一定的限制作用。
先正达选择与Amoéba合作,深层反映了传统农化巨头面对行业变局的战略调整。随着欧盟农药法规日趋严格,化学农药的选择空间不断收窄,而病原菌抗药性又持续削弱现有产品的效力,大型企业不得不加速向生物解决方案转型。这种源自变形虫的创新产品,因其“低风险”特性、无残留优势,完美契合了日益严格的监管要求和食品价值链的可持续发展协议。
从商业布局来看,双方计划在2026年春季达成最终分销协议,并于2028年率先在小麦上实现销售。这一时间表既考虑了欧盟活性物质批准流程(已于2025年6月获得),也为后续产品级注册留出了充足空间。值得注意的是,该产品被设计为易于使用的特性——两年保质期、无特殊储存要求、可与传统产品桶混或轮换使用——显示出生物制剂正从“概念性产品”向“农民友好型实用工具”的实质性转变。
除了谷物作物,Amoéba还在探索该技术在果园、香蕉、马铃薯、草坪乃至家庭园艺中的应用潜力。这种横向扩展的可能性,为其技术平台创造了更大的商业想象空间。

02 商业模式与创业启示
先正达此次布局,为农业科技领域的创业者提供了极具价值的战略启示。首先,创新来源正变得日益多元化。 当大多数人将目光锁定在微生物领域时,Amoéba却从更原始的真核生物——变形虫中找到了解决方案。这提醒创业者,生物学宝库中仍有大量未被开发的资源,从原生动物到海洋生物,突破性技术可能隐藏在任何生命层级中。
其次,监管压力正在重塑产业竞争格局。 越来越严格的农药法规不再是制约,反而成为驱动创新的强大外力。能够提供“合规优势”的技术解决方案,在市场上将获得独特的竞争壁垒。对创业者而言,在设计产品之初就将监管合规性作为核心考量,甚至主动瞄准“低风险”、“零残留”等标签,可能成为切入市场的有效策略。
再者,与传统巨头的合作成为可行的商业化路径。 Amoéba选择与先正达合作,利用其遍布欧洲的渠道网络和市场信誉,而非独自开拓市场。这种“技术公司+渠道巨头”的分工模式,让专注于研发的初创企业能够更专注于技术创新,而将复杂的市场推广和分销交给经验丰富的合作伙伴。这为资源有限的创业者提供了一条被验证的成功路径。
此外,这项技术的成功也凸显了“整合思维”在农业创新中的重要性。该产品并非旨在完全替代化学农药,而是作为现有病害管理方案的补充,通过提升整体方案的可持续性和抗性管理能力来创造价值。这种“兼容并蓄”的定位,降低了农民的采用门槛,也提高了技术的市场接受度。

从变形虫到小麦田,这场微观世界的革命正在重新定义作物保护的未来。它告诉我们,解决现代农业面临的宏观挑战,可能需要从最微小的生命形式中寻找答案。
对于农业创业者而言,这个案例既展示了生物技术在农业领域的巨大潜力,也揭示了一条清晰的成功路径:挖掘独特生物资源、解决明确产业痛点、设计符合监管趋势的解决方案、并找到与产业巨头共赢的合作模式。
当全球农业在粮食安全与可持续发展之间寻找平衡点时,类似变形虫杀菌剂这样的创新技术,正成为那个关键的支点。它们或许不会完全取代传统化学农药,但必将重塑我们的作物保护体系,开创一个更加精准、可持续的农业未来。在这个未来中,最强大的解决方案,可能就隐藏在那些最不起眼的生命形式之中。
游客可直接评论,建议先注册为会员后评论!
以上评论仅代表会员个人观点,不代表中国农药网观点!



